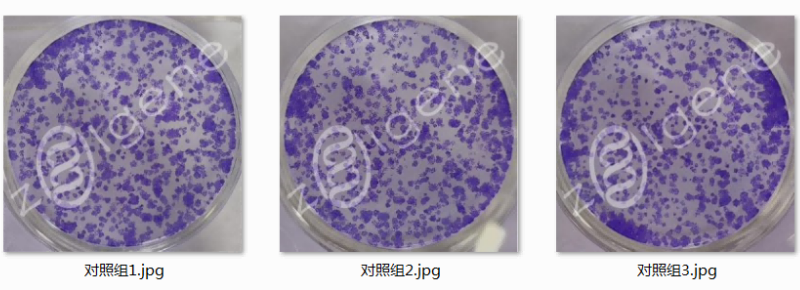
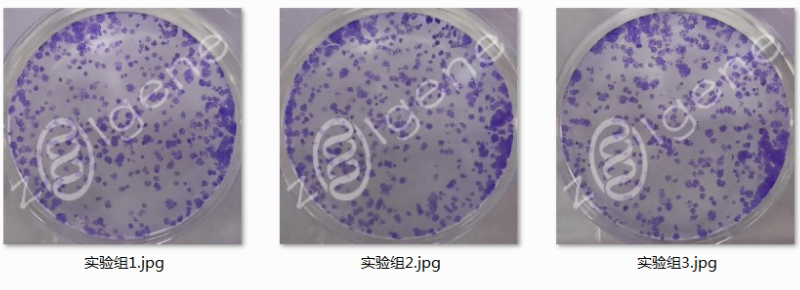

細胞培養環境的改變或藥物、基因等外源性因素的作用能導致細胞克隆形成能力以及細胞集落的大小發生改變,通過平板克隆的實驗方法可以對細胞的克隆形成能力進行檢測。
載基現提供平板克隆形成試驗服務,可用于檢測各種貼壁細胞和正常培養細胞,如骨髓造血干細胞、腫瘤細胞株、轉化細胞系等。
? 服務介紹
細胞培養環境的改變或藥物、基因等外源性因素的作用能導致細胞克隆形成能力以及細胞集落的大小發生改變,通過平板克隆的實驗方法可以對細胞的克隆形成能力進行檢測。
載基現提供平板克隆形成試驗服務,可用于檢測各種貼壁細胞和正常培養細胞,如骨髓造血干細胞、腫瘤細胞株、轉化細胞系等。
客戶提供:細胞株(您可以選擇自己提供,或選擇由載基提供或代購),請用干冰或冰袋運輸樣品;
細胞處理方式及相關試劑。
最終交付:實驗流程及完整報告一份,包括實驗原始數據、圖片、分析結果等。
? 服務流程
? 結果示例